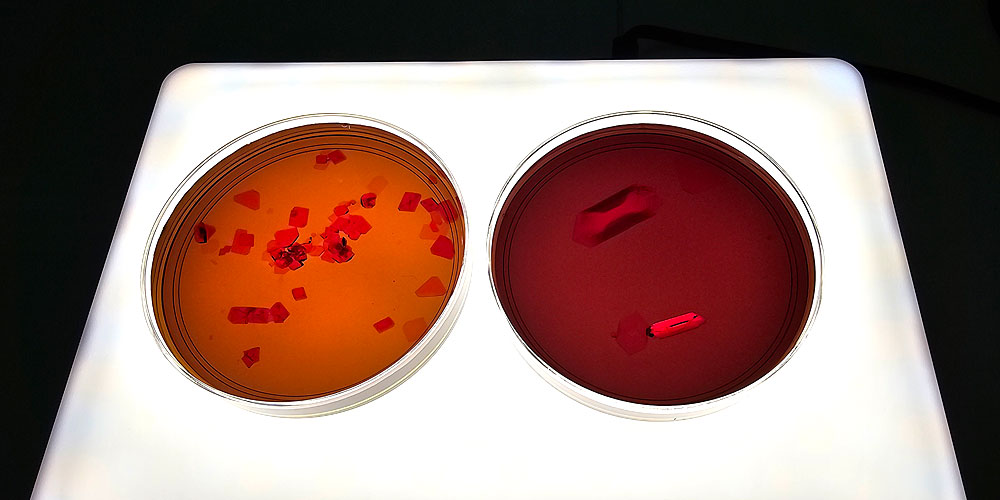
The oxidation of potassium ferricyanide solutions.

You can grow beautiful red crystals from potassium ferricyanide, a blood red salt.
 It is commonly used as an ingredient in cyanotyping – and despite its name, quite safe to handle.
It is commonly used as an ingredient in cyanotyping – and despite its name, quite safe to handle.
Since it’s hard to find household materials that can form red crystals, I was very excited when I got my hands on some potassium ferricyanide.
 A closeup of potassium ferricyanide powder. I love that color!
A closeup of potassium ferricyanide powder. I love that color!
After a year or so, I’ve now grown quite a few crystals with it. In this guide, I’ll share the method I used, several interesting things I discovered, and of course, lots of pretty pics.
Materials
To grow these crystals, you’ll need:
- Potassium ferricyanide powder
- Very hot water
- A glass jar
- A flat dish
- A plastic spoon
- A beaker (or a Pyrex dish)
- Thin nylon fishing line (optional)
- An electronic balance
Make sure all your containers and spoons are non-metal, as the solution reacts with iron ions to form Prussian blue. That’s how cyanotyping works, but we don’t want that to happen.
Safety
It’s safe to handle potassium ferricyanide. As a mild irritant, if you touch it, do wash your hands afterwards.
Also, never add acid to the compound or heat it over 150°C. This will cause it to release highly toxic cyanide gas. Not cool.
Procedure
Now, let’s start growing these crystals!
First, dissolve 50g potassium ferricyanide per 100mL of hot water in a beaker (or any heat resistant, non-metal container), to create a saturated solution.
Now, stir the solution until all the powder dissolves.
Once everything has dissolved, the solution should appear dark brown, almost black.
 Let it cool to room temperature.
Let it cool to room temperature.
Optionally, filter the solution into a new container. You can use a coffee filter – even tissue paper will work.
Filtering helps to get rid of dust and impurities in the solution that can mess with the crystal growth.
After that, pour about 30mL of solution into a small, flat dish.
 Leave it overnight.
Leave it overnight.
The next day, small red crystals should have formed in the dish. These are pure potassium ferricyanide crystals.
For me, only one crystal formed at first.
 Then on the second day, a bunch of others started popping up.
Then on the second day, a bunch of others started popping up.
 Some of you might run into one of two problems at this step. Both are easy fixes:
Some of you might run into one of two problems at this step. Both are easy fixes:
- No crystals are forming inside the dish
Your solution is not saturated enough. Try reheating the solution and dissolving more power inside. Then repeat the procedure.
- Red dust is forming on the surface of the solution and inside the dish
The dust actually contains thousands of tiny crystals. Why?
Because the solution is too saturated (you dissolved too much powder). This might be more common if you live in a colder place, as cold water can dissolve less powder compared to hot water.
To fix this, try reheating the solution, and diluting it with about 10% more water vs the total volume of the solution. This should dissolve all the dust.
Regardless, once crystals do form, you can proceed with the next step:
Choose a decently sized one, and tie it to a nylon fishing line attached to a pencil/stick.
 Hang the crystal in the solution you prepared earlier.
Hang the crystal in the solution you prepared earlier.
Place the setup somewhere undisturbed and dark (prolonged exposure to light will cause it to decompose, more later).
Now, all we need to do is to wait.
After 1 week, here’s what my crystal looks like:
 I placed a light behind the solution – otherwise it is too dark to see the crystal.
I placed a light behind the solution – otherwise it is too dark to see the crystal.
You can keep growing it as long as you have enough solution. But after 2 weeks my crystal was already touching the surface of the solution, so I had to take it out.
 Beautiful!
Beautiful!
But we’re not done yet.
At this point, the leftover solution should have become darker than before. This is because potassium ferricyanide solutions decompose under sunlight, or when left standing in air.
Left: Fresh solution, Right: Dark solution (left for 1 month)
Left: Fresh solution, Right: Dark solution (left for 1 month)
For some reason, crystals that grow from darker solutions are longer and more needle-like.
If you try hanging another small crystal into this dark solution and let it grow for one week, the crystal will look like this:
 It’s very hard to grow single crystals from darker (and hence spikier) solutions.
It’s very hard to grow single crystals from darker (and hence spikier) solutions.
 Left: Crystal grown from fresh solution, Right: Crystal grown from dark solution
Left: Crystal grown from fresh solution, Right: Crystal grown from dark solution
Instead, you can take advantage of this spikiness to grow crystal clusters instead.
Here’s how to do it:
Pour the dark, leftover solution into another container. I used a glass dish.
 In this case, there is no need to hang a seed crystal inside the solution. Just let the crystals form naturally at the bottom of the container.
In this case, there is no need to hang a seed crystal inside the solution. Just let the crystals form naturally at the bottom of the container.
After a week, pour away the solution, and you should see clumps of long, red crystals.
 You can stop here if you’re satisfied.
You can stop here if you’re satisfied.
If you want to grow them even bigger, select a nice cluster:
 Then, place it at the bottom of a new dish filled with more potassium ferricyanide solution.
Then, place it at the bottom of a new dish filled with more potassium ferricyanide solution.
The reason we isolate this specific cluster is that this will allow it to grow much faster.
Wait another week, pour away the solution once again.
You should see something like this:
 We see exotic crystals online, and in shops, but it’s incredible how you can just grow these at home.
We see exotic crystals online, and in shops, but it’s incredible how you can just grow these at home.
That’s all for this guide.
If you plan on doing it yourself, then have fun! Feel free to leave your questions in the comments below.
And if you manage to grow some nice crystals, do share them with me! I’d love to feature them on this website. I’m planning to create a new page showcasing crystals that others have grown.
To see more cool crystals, consider visiting my dad’s YouTube channel, or check out this article on how to grow alum crystals.
As always, happy growing!
how long does it take?
Depending on the size of the crystal, a few days to a few weeks. The crystal in the first picture in this article took 2 weeks.
question.
if I used metal stuff for this, could I grow blue crystals?
The compound formed from the reaction is Prussian blue, which is a dark blue precipitate that isn’t soluble in water, so you can’t grow crystals with it. Although if there is a very small amount present in the saturated potassium ferricyanide solution, it might coat the otherwise red crystals and make them appear dark blue.
How would you go about storing crystals of potassium ferricyanide? Do they oxidise if left in open air, or are they stable in air?
These crystals are stable in air, so you don’t need to store them under any special conditions. Do keep them out of bright sunlight, as they break down in the presence of light.
Thank you so much! I tried this crystal as well as the chrome alum one and they are growing beautifully! I’m just curious as to how you know what chemicals are best for crystal growing, and whether or not you can predict the shape before hand.
They are pretty standard crystal growing compounds. You can find a list on the Crystal Growing wiki, or browsing through r/crystalgrowing on Reddit.
Each compound has its own characteristic crystal structure, so yes, you can predict the shape beforehand. Just Google pictures of crystals of the same compound. On the other hand, if it is a new compound and there are no pictures online… then you can be the first to discover it 🙂
Got it, thank you so much!
Im so sad i haven’t seen this earlier im already doing potassium aluminum crystal for my project this looks so much cooler i recently got into crystals. You are my inspiration 🙂
Don’t be sad, alum is pretty cool too. It literally looks like a diamond. Good luck!
I really enjoyed the videos on your dad’s channel and they helped excite me to get back to crystal-growing, which I absolutely loved doing as a child. Very happy to see posts on this blog after 4 years! Potassium ferricyanide crystals are very stunning.
I’m glad you liked them! I wish I discovered this hobby as a child. I’m still quite active here, it’s just that it’s not so convenient for me to grow crystals at the moment, so there haven’t been many posts lately.
Thank you so much! This is wonderful & I am going to try it!
Have fun!